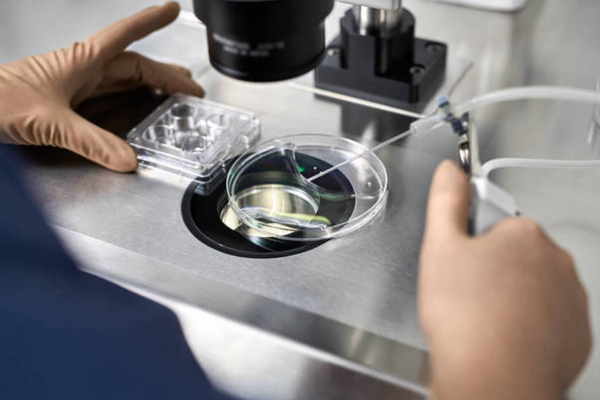
7c5c2a5020da6695b5813999da03713e.png 上海做试管婴儿能不能选性别呢

现在很多人都想有一个儿子和一个女儿。所以,当他们第一个孩子是女儿的时候,第二个孩子就想生个儿子。这种情况下,他们会把希望寄托在试管婴儿上。那么,二胎生男孩,到上海做试管婴儿能不能选性别呢?
植入前遗传诊断,简称PGD,也称为第三代试管婴儿,用于确定胚胎的基因在试管婴儿治疗周期中是否异常。基因诊断也可以用来帮助鉴定胚胎的性别。在这种情况下,是不是就可以做第三代试管婴儿选择胎儿的性别呢?这是不可能的。
首先,国家法律严禁非医学需要的性别鉴定和选择。只有当出生的女孩或男孩患有某种疾病时,性别选择才会被允许选性别。其次,第三代试管婴儿不是想做就能做的,有严格的适应症,且比第一代和第二代试管婴儿成本更高。
随着辅助生殖技术的发展,技术上已经实现了性别筛查,但在我国受到法律的限制,需要满足严格的指征才能做第三代试管婴儿来选择后代的性别,从而减少遗传病的发生。
第三代试管婴儿会通过特殊的方法分析筛查胚胎是否有遗传疾病细胞,进而避免性连锁遗传病的胚胎被植入女性子宫内。如果没有性别诊断判断的医学指征,医院是无法实施这项技术的。另外,针对一些有传女不传男,传男不传女的遗传性疾病,也可以通过第三代试管婴儿来筛选性别。比如血友病、蚕豆病、II型糖尿病等。通过基因筛查,能够促使夫妻生下健康的宝宝。

对此,在上海及其他地区,要二胎的夫妻如果想要做试管婴儿,除了有家族遗传病史、染色体异常等可以选择胎儿性别,其他的一律不可选择胎儿性别。而且为了生男孩或生女孩做基因筛查也是没有必要的,只要宝宝健康就好了。
